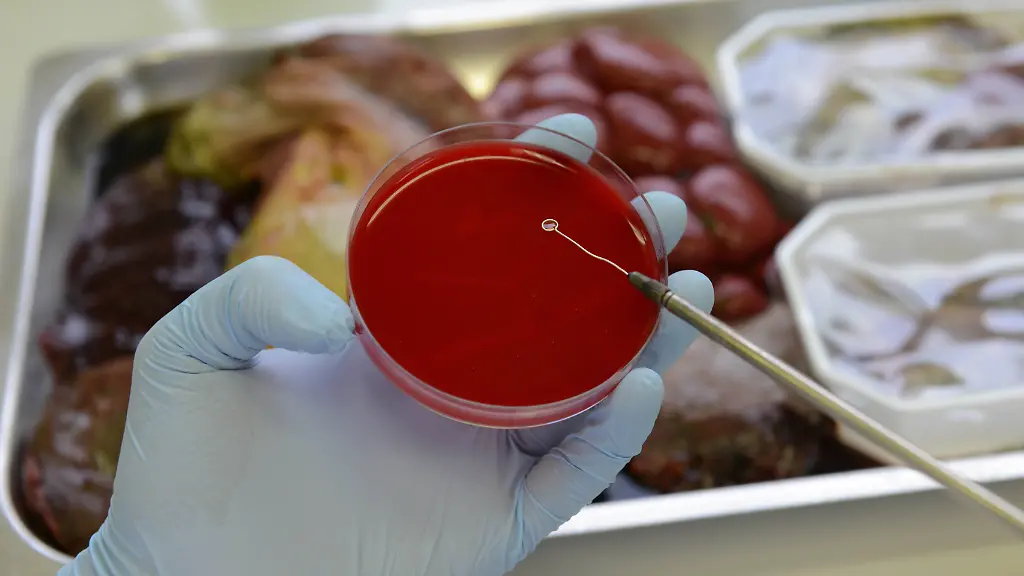

Prionen-Risiko in der Haut?Forscher kommen Creutzfeldt-Jakob näher
Das Phänomen ist auch als "menschlicher Rinderwahn" bekannt: Die Creutzfeldt-Jakob-Krankheit ist extrem selten, aber tödlich. Bisher war die fehlerfreie Diagnose enorm kompliziert. Neue Ergebnisse aus der Forschung könnten das nun ändern.
Verformte Proteine, die das Gehirn verklumpen lassen - sie gelten als die Auslöser der tödlichen Creutzfeldt-Jakob-Krankheit (vCJK) beim Menschen. In einer Studie haben Wissenschaftler nun Hinweise darauf gefunden, dass die abnormalen Proteine auch in der Haut infizierter Menschen nachweisbar sind. Die in der Fachzeitschrift "Science Translational Medicine" veröffentlichten neuen Erkenntnisse könnten auf bisher unbekannte Übertragungswege der Krankheit hinweisen, heißt es in Fachkreisen. Charakteristisch für vCJK ist, dass die abnorm gefalteten Prionproteine sich vor allem im Gehirn ansammeln.
Angst vor einer Übertragung der Krankheit durch einen einfachen Hautkontakt müsse man allerdings nicht haben, sagen die Experten. Ein solches Risiko sei höchst unwahrscheinlich, weil die Konzentration des fraglichen Eiweißes in der Haut deutlich geringer sei als im Gehirn, schrieben die Forscher von der "Case Western Reserve School of Medicine". Allerdings könnte es möglich sein, Patienten durch andere operative Eingriffe zu infizieren, die nicht das Gehirn beträfen. "Es ist bekannt, dass vCJK mittels chirurgischer und medizinischer Eingriffe, die mit fehlerhaften Proteinen infiziertes Gehirngewebe betreffen, übertragen werden kann", erklärt Wenquan Zou, Hauptautor des Artikels.
Neues Wissen könnte Diagnosen erleichtern
Das neue Wissen um die Nachweisbarkeit der atypischen Eiweiße könne aber auch helfen, einfachere Möglichkeiten der Diagnose der menschlichen Form von Rinderwahn zu entwickeln, heißt es in der Studie. Untersuchungen der Haut "vor oder nach dem Tod" eines Patienten könnten somit die Diagnose von vCJK ermöglichen, folgerte der Neurologe und Pathologe Wenquan. Bislang erlaubt lediglich eine Gehirn- oder Rückenmarkuntersuchung die fehlerfreie Diagnose der Krankheit. Die Ansteckungsrate ist gering: Jährlich tritt derzeit Schätzungen zufolge weltweit nur ein Infektionsfall unter einer Million Menschen auf.
Die menschliche Form von Rinderwahn ist unheilbar. vCJK führt zu eine fortschreitenden Zersetzung des Gehirns und löst plötzlichen Erinnerungsverlust, Steh- und Bewegungsstörungen sowie Verhaltensveränderungen aus. Patienten sterben meist innerhalb eines Jahres an der Krankheit.
Der sogenannte Rinderwahnsinn BSE weist ähnliche Symptome auf. Es wird vermutet, dass sich viele vCJK-Opfer durch den Verzehr von BSE-verseuchtem Rindfleisch anstecken. Doch auch die bei Hausrindern vorkommende Krankheit gilt als sehr selten. Zudem ist vermutlich eine Mehrheit der Bevölkerung resistent gegen eine Übertragung durch die Aufnahme BSE-verseuchter Nahrung.